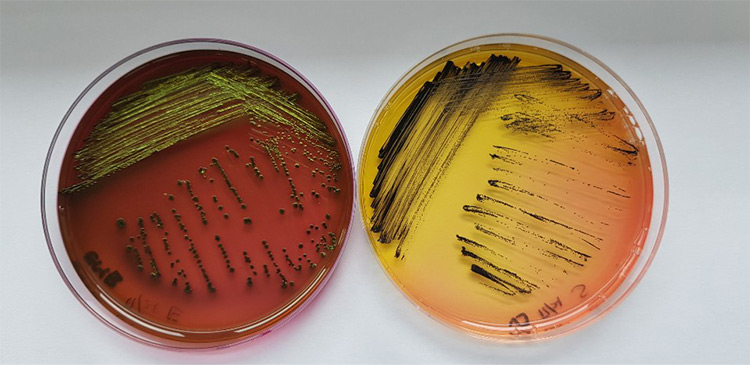
화장품 미생물 한도 시험

화장품 미생물 한도 시험
HOME > 시험 항목 > 화장품 미생물 한도 시험
화장품 미생물 한도 시험
오염도 시험, 생균수 시험 등으로도 불리는 미생물 한도시험은 화장품에 존재하는 일반 미생물 수와 특정 미생물의 존재 유무를 판단하여 화장품이 소비자 사용에 안전한지를 평가하는 시험입니다.
우리나라에서는 식품의약품 안전처 고시로 시험방법과 국내 허용 기준을 정하고 있습니다.(고시 제2019-27호 참고)
화장품의 미생물 한도 기준(국내)
1) 총 호기성 생균수는 영 · 유아용 제품류 및 눈 화장용 제품류의 경우 500개/g(mL) 이하
2) 물휴지의 경우 세균 및 진균수는 각각 100개/g(mL) 이하
3) 기타 화장품의 경우 1,000개/g(mL) 이하
4) 대장균( Escherichia coli ), 녹농균( Pseudomonas aeruginosa ), 황색포도상구균( Staphylococcus aureus )은 불검출
화장품 미생물 한도 시험 소요 기간
1) 미생물 한도 시험 소요 기간 : 7 일
☞ 특정 미생물 시험에서 미생물이 검출되는 경우에는 균 동정을 위한 추가 시험 진행으로 상기 시험 기간보다 더 많은 시간이 필요하므로 시험 담당자와 협의바랍니다.
2) 보고서 작성 기간 : 3일
화장품 미생물 한도 시험에 필요한 시료 량
최소 30g
대장균( Escherichia coli ), 황색포도상구균( Staphylococcus aureus )


